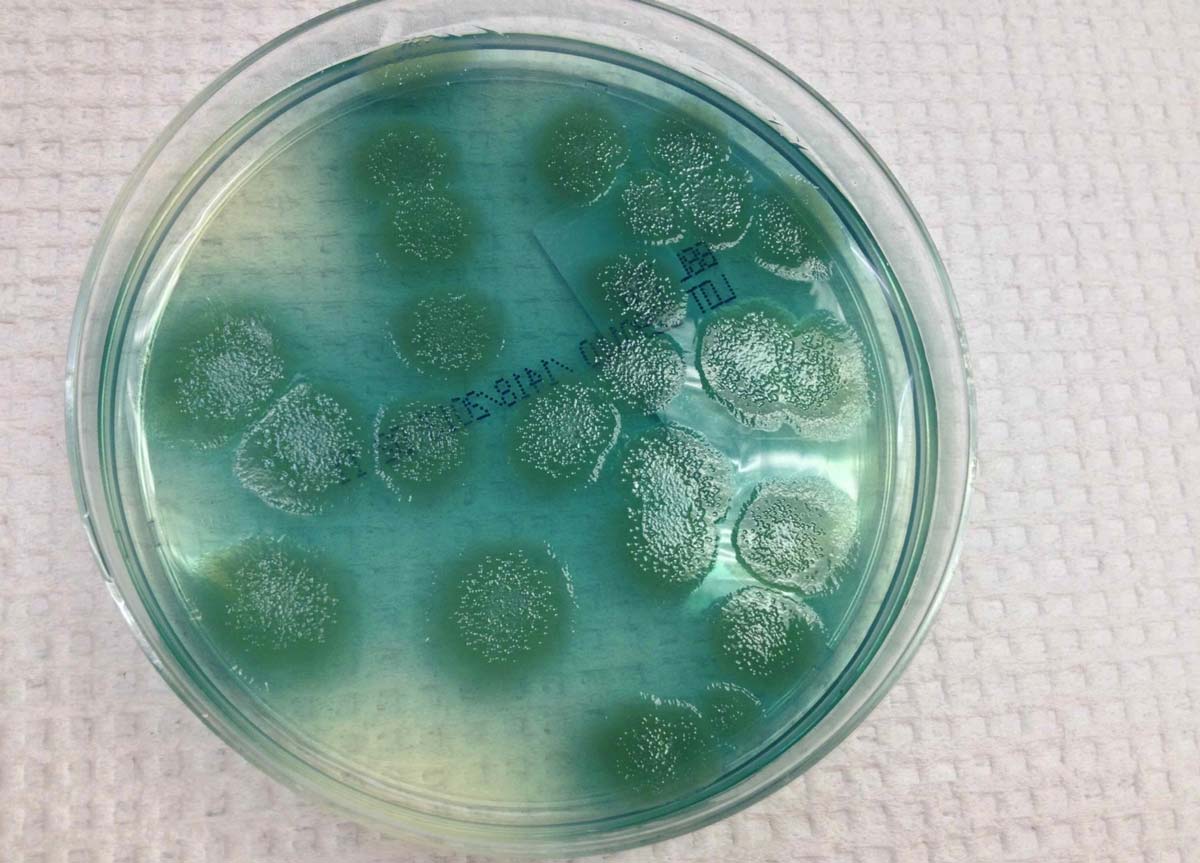

SQLITE NOT INSTALLED
Почему у кошки текут глаза – возможные причины.
У обычной здоровой кошки всегда выделяется прозрачный жидкий секрет из органов зрения, но он почти незаметен. Считаются нормой и те редкие случаи, когда у питомца проявляется обильное слезотечение. Такое бывает из-за негативного влияния внешних факторов, таких как дым, пыль, резкое освещение или едкие химикаты, несоблюдение гигиены. Как правило, после того как кошка возвращается в нормальную среду обитания без внешних раздражителей, выделение слез прекращается.
Волноваться стоит, когда у кошки появляются темные выделения из глаз, поскольку это является прямым свидетельством наличия инфекции в организме животного. Если вы заметили у своей любимицы мутные, коричневые, белые или красные выделения, незамедлительно обратитесь за помощью к специалисту и не пытайтесь лечить животное самостоятельно в домашних условиях.
В случае наличия в организме животного не вирусной, а бактериальной инфекции, вы заметите выделения из глаз, отличающиеся от слез. Они также могут быть белого и желтоватого оттенка, и провоцируют воспаление в этой области.
Существует целый ряд заболеваний, которые могут стать причиной нарушения работы слезоотводящих каналов у кошек:
- Это образование опухолей и новообразований, которые пережимают каналы.
- Аллергия на внешние раздражители или на пищу. Эта причина является одной из наиболее распространенных.
- Неинфекционное воспаление слезного мешка.
- Физическая травма глаз.
- Инородный предмет, который попал в просвет слезного канала.
- Стеноз слезных точек.
- Сужение слезных каналов из-за воспалительных процессов в организме.
- Инфекционные конъюнктивиты.
- Воспаление век.
- Неправильный рост ресниц (трихиаз).
- Повреждение роговицы.
- Заболевание глазных сосудов.
- Глаукома.
- Предрасположенность породы. Некоторые породы кошек, такие как персидская или британская, имеют брахицефалическое строение черепа, из-за чего у них укороченный слезной канал и повышенное слезовыделение.
- Глистные инвазии.
- Проблемы с иммунитетом. Наиболее часто встречается у котят и старых кошек, которые часто простужаются, из-за чего у них наблюдается обильное слезотечение.
Не забывайте о том, что какой бы не была причина заболеваний, длительное отсутствие надлежащего лечения усугубит ситуацию. Все это время животное будет испытывать дискомфорт. Как результат, кошка начнет чесать больной глаз, расчесывая его до ранок и увеличивая область заражения микробами.
Массаж при дакриоцистите новорожденных
При формировании органов слезный проток заполняется эпителиальной тканью, а выход мембранной пленкой. При рождении у новорожденного повышается давление, которое выталкивает слизистую массу из канала и разрывает мембрану.
Если ребенок слабенький или есть аномалии развития, пленка не разрывается. Это приводит к дакриоциститу. Дакриоцистит — распространенная проблема у грудничков. Основным методом лечения является массаж глаз. Он стимулирует отток жидкости и гнойного экссудата, скопившихся в слезном мешке.
Рекомендуем почитать: Дакриоцистит у взрослых
Эффективность массажа
Показаниями к выполнению массажа служат классические признаки дакриоцистита:
- слезотечение;
- отечность;
- гнойные выделения.
Процедура назначается офтальмологом, после проведения обычного осмотра новорожденного. Окулист дает рекомендации относительно техники массирующих движений.
Эффективность процедуры состоит в более быстром удалении остатков слез и гноя. Он предотвращает развитие инфекционного процесса.
Мягкое и щадящее механическое воздействие на железу — самый эффективный метод устранения закупорки канальцев и облегчения выхода жидкости. Способ позволяет предотвратить хронизацию процесса.
Подготовка к массажу
Особой подготовки к процедуре не требуется. Перед манипуляцией ребенок не нуждается в применении обезболивающих препаратов. Не нужно медицинское оборудование для выполнения массажа.
Процедура проводится на приеме офтальмолога. Изначально родители смотрят, как правильно выполнять массирование, затем окулист покажет, как правильно делать массаж новорожденному.
К процедуре готовится мама. Необходимо коротко остричь ногти и тщательно вымыть руки, желательно с антибактериальным мылом. Если руки холодные, согреть. На пальцы перед массажем наносят крем или масло, так его проще проводить. Понадобится косметический спонж и антисептическое средство.
Перед тем, как приступить к манипуляции веки малыша осторожно промывают. Косметический спонж смачивают антисептиком и протирают от наружного угла к переносице. Для каждого глаза используется отдельный спонж
Для каждого глаза используется отдельный спонж.
Пошаговая техника массажа при дакриоцистите
Выполнение процедуры следует выполнять осторожно, чтобы не навредить малютке. Массаж не следует проводить самостоятельно, если врач не показал, как это делается. В домашних условиях его выполнение разрешается только после обучения
В домашних условиях его выполнение разрешается только после обучения.
Офтальмолог должен провести первый сеанс самостоятельно, рассказать родителям о тонкостях процедуры.
Схема несложная. Главное — соблюдать рекомендации доктора. Пошаговая техника:
- Смазать палец кремом, не использовать много, чтобы у малыша не возникло раздражение. Выполняется массаж мизинцем, средним или указательным пальцем.
- Найти слезный канал. Он находится между внутренним углом глаза и бровью. Палец следует расположить выше внутреннего уголка.
- Выполнять скользящие движения с небольшим надавливанием от уголка зрительного органа по направлению к крылу носа. Сделать 10 повторений.
- Движения направляют на прорыв пробки. Таким образом, создается давление, которое пытается разорвать мембрану.
- Массирование заканчивается спиралевидными движениями, но в обратном направлении. Пальцем рисуют спиральки, одновременно надавливая на глазки. Двигаться от внутреннего уголка к бровям.
- Новорожденного положить на бок, повторить движения с 3 пункта по 5.
Во время процедуры выделяются слезы и гной. Убирать их чистым ватным тампоном, спонж чаще менять.
Важно не касаться слизистой оболочки, не оказывать дополнительного давления во время процедуры. Завершается сеанс закапыванием капель. Усилить эффективность массажа можно глазной гимнастикой
Свет в комнате не должен быть ярким до полного выздоровления
Усилить эффективность массажа можно глазной гимнастикой. Свет в комнате не должен быть ярким до полного выздоровления.
Противопоказания
Воздействие на зрительные органы запрещается выполнять, если у ребенка есть гнойное воспаление, закупорка слезных мешков. Данные патологии присутствуют лишь при запущенной степени дакриоцистита либо при неправильной схеме лечения.
Массаж нельзя начинать ранее 14-х суток со дня рождения малыша. У большинства деток желатинозная пробка самостоятельно рассасывается и воспаление проходит. Если ко 2 неделе улучшение не произошло, прописывают лекарства и назначают массаж.
К другим противопоказаниям относят:
Если данных противопоказаний нет, заболевание хорошо поддается лечению без госпитализации.
Почему слезятся глаза (причины повышенного слезоотделения)
Глаза начинают слезиться, когда мы попадаем в условия, которые могут причинить глазам вред. Это нормальная рефлекторная реакция. Увеличением слезоотделения организм реагирует на:
-
попадание в глаз инородного тела;
-
дым и едкие газы;
-
погодные условия – сильный ветер, холодный воздух, снег;
-
яркий свет;
-
чрезмерную сухость воздуха в помещении;
-
некоторые приправы.
Достаточно условиям нормализоваться — и глаза перестанут слезиться. Однако, наряду с рефлекторной реакцией, существуют и патологические причины слезотечения, например:
-
аллергия. Контакт с аллергеном может вызывать воспаление конъюнктивы, одним из симптомов которого является слезотечение. Глаза могут начать слезиться в период цветения растения-аллергена (при поллинозе). Это также может быть реакция на косметику, бытовую химию, контакт с животным и т.д.
-
инфекция. Инфекция может попасть в глаза через слезно-носовой проток, в этом случае воспаление структур глаза может быть осложнением ОРВИ. Возможны и другие пути проникновения. К инфицированию, в частности, может привести неправильный уход за контактными линзами. В воспалительный процесс могут быть вовлечены конъюнктива (конъюнктивит), веки (блефарит), роговица (кератит);
-
нарушение оттока слезной жидкости. Если слезоотводящие пути сужены или перекрыты, слезная жидкость не может попасть в носовую полость, и накапливается в глазу. Подобное состояние может быть следствием травмы или хронических заболеваний носовых ходов (хронический ринит, хронический синусит, носовые полипы, аденоиды). То, что у пожилых людей слезятся глаза, как правило, объясняется именно проблемами со слезоотводящими путями. Повышенная чувствительность к холоду также может объясняться этой причиной: при холоде мышцы сжимаются, и если слезоотводящие пути сужены, они могут полностью перекрываться, мешая оттоку слезы.
-
чрезмерное утомление глаз. Если глазам приходятся напрягаться, они могут начать слезиться. Поэтому причиной слезотечения могут быть неправильно подобранные очки или линзы; работа, при которой приходится усиленно вглядываться и т.д.
-
недостаток калия и витаминов группы B. Дефицит этих веществ приводит к повышенной утомляемости, сонливости, светобоязни и слезотечению. Дефицит может быть вызван хроническим недосыпанием или активными физическими нагрузками.
Какие типы косоглазия бывают?
В норме оси обоих глаз человека должны быть параллельны. Если у малыша отмечается несимметричный взгляд, можно говорить о косоглазии, которое, в свою очередь, делится на типы. Оно бывает горизонтальным, вертикальным и комбинированным.
Типы косоглазия:
-
горизонтальное косоглазие — глазки могут сходиться к переносице или наоборот, расходиться, тяготея к височной зоне;
-
вертикальное косоглазие — глазная мышца в этом случае не может удерживать глаз и он отклоняется вверх или вниз;
-
комбинированное — это вертикально-горизонтальное поражение глазодвигательного аппарата;
-
паралитическое и содружественное — при паралитическом недуге отмечается паралич одной или нескольких двигательных мышц глаза, а при содружественном глазные яблоки сохраняют свою подвижность без паралича, парезов — это лечится ношением очков, сеансами аппаратной терапии.
Гиперфункция нижней косой мышцы глаза является главной причиной того, что при содружественном косоглазии по сходящемуся типу отмечаются отклонения вверх. Вертикальная девиация сложно поддается лечению и обычно требует оперативного вмешательства. При врожденном косоглазии она диагностируется в 90% случаев.
Среди причин появления преобладают: перенесенные инфекционные заболевания, парез глазной двигательной мышцы, травмы головы. При дальнозоркости наиболее часто отмечается сходящееся косоглазие, а при близорукости — расходящееся.
При альтернирующем косоглазии косят оба глаза периодически. При монокулярном — один глаз. Если болезнь своевременно не диагностировать и не лечить, может развиться амблиопия — синдром «ленивого глаза», когда информация от косящего глаза игнорируется мозгом.
При коррекции очками здоровый глаз необходимо закрывать, чтобы глаз с амблиопией стал фиксирующим. Чтобы он снова включится в работу, косоглазие корректируется очками, в ряде случаев маленькому пациенту рекомендуется операция.
Диагностика в ветеринарной клинике
Выделение из глаз котёнка гнойного экссудата может быть не только глазной болезнью, но и сигналом об опасной инфекции в организме питомца. Лучший выбор ответственного владельца — это незамедлительное посещение ветеринарной клиники. Иммунитет котёнка очень слаб и без оказания квалифицированной лечебной помощи развитие инфекции может погубить питомца.
При диагностике проводится:
- осмотр больного котёнка на наличие инородных тел или травматических повреждений глаза;
- выяснение причин, раздражающих слизистую оболочку глаза;
- характер и периодичность гнойных выделений;
- микроанализ смыва со слизистой оболочки глаза;
- анализ мочи, кала.

В зависимости от состояния животного и природы возникшего недуга, врач может назначить:
- УЗИ поражённого глаза;
- рентгенографию черепа;
- осмотр на офтальмоскопе.
Что делать в домашних условиях
В домашних условиях необходимо строго соблюдать все назначения врача, хранение лекарств обеспечить в соответствии рекомендаций медицинских аннотаций.
Для создания условий, благоприятных выздоровлению, нужно обеспечить питомцу тёплое спальное место в тихом уголке без сквозняков.
Большое значение имеет питание: следует дополнить рацион витаминными добавками и обеспечить его сбалансированность.
Перед проведением процедур владельцу важно тщательно мыть руки с мылом, а для очистки каждого глаза котёнка от загрязнений использовать отдельные салфетки. При применении в лечении или очищении растворов, температура жидкостей должна быть не ниже 37 градусов
В помещении, где располагается котёнок во время лечения обязательны:
- ежедневная влажная уборка;
- замена подстилок на спальном месте животного;
- контроль температуры тела;
- контроль состояния глаз.
Зачем человеку слезы
Слезная жидкость по своему составу сопоставима с плазмой крови, отличаясь тем, что содержит больше калия и хлора и меньше органических компонентов. На 99% процентов слезы состоят из воды. В зависимости от состояния нашего здоровья состав слезной жидкости может меняться, поэтому иногда ее берут для анализа.
Основными функциями слез являются:
- увлажнение слизистых глаза и носоглотки. Покрывая глаз тончайшей пленкой, слезная жидкость защищает его от вредных воздействий внешней среды. При возрастании агрессивности среды (например, в случае присутствия в воздухе дыма) или попадании в глаза инородного тела (соринки) слезоотделение увеличивается, и слезы вымывают из глаза то, что может причинить ему вред;
- антибактериальная. В состав слезной жидкости входит фермент лизоцим, способный эффективно уничтожать бактерии. Благодаря лизоциму глаза оказываются надежно защищены, несмотря на постоянный контакт с внешней средой;
- антистрессовая. Со слезами из организма выводятся гормоны, выработкой которых организм отвечает на стрессовые ситуации. Именно поэтому слезы являются типичной реакцией на сильное эмоциональное возбуждение: высокая концентрация гормонов может угнетать нашу психику, и природа предусмотрела возможность избавиться от их излишка с помощью слез. Не случайно в народе говорят: поплачь – легче станет. Этот же механизм включается и при избытке адреналина (так называемые «слёзы радости»);
- слёзы обеспечивают питание роговицы, лишенной кровеносных сосудов.
Аллергический конъюнктивит у ребенка
Эта форма конъюнктивита индивидуальна и не передается через контакты или воздух. Вызвать раздражение глаз могут различные аллергены:
- пыльца цветущих растений;
- шерсть и пух животных;
- продукты, лекарственные препараты;
- бытовая химия и т.д.
Как только конкретный аллерген попадает на слизистые оболочки ребенка, организм сразу начинает реагировать на него. Глаза воспаляются и краснеют, появляется зуд, слезотечение, отек носа и век, светобоязнь, кашель. Вот какие факторы могут вызывать данную патологию.
Поллиноз, или сезонный аллергический риноконъюнктивит. Возникает в весенний и летний периоды при цветении некоторых растений. При поллинозе может развиться аллергический дерматит, а также для него характерны повышенная утомляемость, слабость. Для лечения назначают антигистаминные средства, в тяжелых случаях дополняя их кортикостероидами.
- Лекарственный конъюнктивит. Возникает во время приема каких-либо препаратов. К стандартным признакам аллергии могут также присоединиться кожные высыпания, сильный отек слизистой носа. При появлении такой формы конъюнктивита у ребенка следует немедленно прекратить прием лекарственных препаратов и обратиться к офтальмологу для выяснения обстоятельств.
- Хроническая аллергия. Это заболевание может сопровождать человека всю жизнь, так как проявляется на любые, самые обычные компоненты: домашнюю пыль, шерсть животных, косметику и т.д. Раздражающая реакция может возникнуть в любой момент при контакте с аллергеном. После устранения раздражителя симптомы проходят.
Маленьким детям для лечения аллергического конъюнктивита назначают капли, снимающие отек и раздражение, например, «Визин», а также антигистаминные «Аллергодил», «Алезастин», «Олопатадин». Они позволяют уменьшить проявления болезни.
Если они подходят, то симптомы начнут проходить уже на второй-третий день. Если же этого не происходит, обратитесь к врачу — он выпишет другое средство.
Заразен ли конъюнктивит?
Как и другие инфекционные заболевания, все виды вирусного и бактериального конъюнктивита заразны. Болезнь опасна не только для детей в 2 или 3-4 года, но и для взрослых, потому что протекает остро, зачастую с осложнениями. Болезнь может передаваться как бесконтактным способом, по воздуху, так и через предметы общего пользования. Часто конъюнктивит является следствием основного вирусного заболевания, например, ветряной оспы, краснухи, кори. В этот период больной ребенок может представлять эпидемическую угрозу для остальных детей, поэтому общение с коллективом следует ограничить.
Как не заразиться конъюнктивитом от больного 2-х или 3-х летнего ребенка:
- исключить использование общих предметов быта, постельных принадлежностей, а также полотенец и платков, посуды;
- регулярно менять постельное белье детей, стирать его, выбирая высокий температурный режим;
- необходимо проглаживать наволочки, носовые платки, которыми пользуется ребенок;
- тщательно мойте руки перед и после выполнения лечебных манипуляций: закапыванием глаз, закладыванием мази, промыванием век и т.д.;
- посуду ребенка необходимо замачивать, мыть, а затем обдавать кипятком.
Как долго длится конъюнктивит у детей? Вирусные конъюнктивиты, которые развиваются изолированно, без простуды, инфекционного заболевания, опасны, но при своевременно начатом лечении проходят быстро, в течение недели. Бактериальный конъюнктивит протекает тяжело.
Заболевшие в 2 года дети испытывают сильные болезненные ощущения из-за неприятных процедур, связанных с очищением глаз от гнойного отделяемого, которое при бактериальной инфекции выделяется обильно.
Дакриоцистит глаз у новорожденных
Еще одна распространенная глазная патология в младенческом возрасте — дакриоцистит. Это непроходимость слезного канала, при которой происходит застой в нем слезы. Всего таких канальцев два — со стороны верхнего века и нижнего. 90% слезной жидкости стекает через нижний канал в нос, дополнительно увлажняя его изнутри. Вот почему, когда мы плачем и происходит усиленное слезотечение, возникает насморк.
До появления ребенка на свет его слезные каналы имеют тонкую перепонку из эмбриональной ткани. Она защищает зрительные органы от попадания в них околоплодных вод. Обычно эта пленка разрывается после рождения, когда малыш делает первый вдох, а его глазки начинают нормально работать. Однако бывает так, что пленка никак не хочет разрываться, и тогда нормальный отток слезы нарушается, присоединяется инфекция и возникает дакриоцистит — гнойное воспаление слезного мешка. Вот основные проявления этой болезни у новорожденного:
- гнойное отделяемое из глаз малыша на второй неделе жизни;
- покраснение конъюнктивы и кожи у внутреннего уголка глаза;
- болезненная припухлость, отек век;
- слезотечение;
- выделение гноя при надавливании на область слезного мешка;
- склеенные после сна ресницы;
- временный эффект от использования антибиотиков и антисептиков.
Внешне проявления болезни напоминают конъюнктивит глаз, и родители часто практикуют самостоятельное лечение: промывание глаз настоем ромашки или чая, закапывание антибактериальных капель. На некоторое время симптомы исчезают, а затем повторяются вновь. Поскольку основная причина не ликвидирована, слеза продолжает застаиваться, в глазную щель попадают новые бактерии и начинают размножаться.
Каждый раз при появлении у ребенка гнойных выделений из глаз не нужно искать советов в интернете, стоит посетить окулиста для диагностики. Только специалист определит, какая патология вызвала воспаление: конъюнктивит, дакриоцистит или что-то другое. Стандартные схемы терапии воспалительных заболеваний глаз включают промывание органов зрения, введение капель и мазей. Врач также может дополнительно назначить массаж глаз при забитом слезном канале, чтобы эффективнее удалить излишки гноя. Его могут проводить родители самостоятельно в домашних условиях. Массаж — важная процедура на начальном этапе лечения конъюнктивита глаз и дакриоцистита, так как он воздействует на причину и направлен на улучшение проходимости слезных путей.
Как лечить бактериальные инфекции, если продуло глаза?

Если глаз опухает, это часто сопровождается поражением зрительных органов бактериями. В таких случаях окулисты назначают бактерицидные и антибактериальные препараты. Это могут быть глазные капли и мази. Часто бывает так, что одно и то же лекарственное средство выпускается в двух формах: мази и капли. Разница между ними заключается в эффективности применения и удобстве использования. Преимущество мазей в том, что они могут довольно долго оставаться на слизистой оболочке глаза. Но мазь часто вызывает дискомфорт, потому многие люди предпочитают лечить припухлость века с помощью глазных капель. Оптимальный вариант терапии — днем использовать капли для глаз, а ночь закладывать мазь за веко.
Если на глазу возник ячмень, то обычно эта проблема проходит самостоятельно. Медикаментозная терапия требуется редко, только после того, как произойдет разрыв гнойника. В остальных случаях — при бактериальных формах конъюнктивита, блефарита, кератита — антибактериальная терапия необходима. Обычно для снятия опухлости века назначаются такие лекарственные препараты, как: «Альбуцид», «Тетрациклин», «Софрадекс», «Флоксал», «Витабакт».
Для взрослых и детей применяются разные глазные капли, если надуло ветром глаз. Различие между ними заключается в составе и свойствах препарата. Лечение взрослых включает в себя использование следующих лекарственных средств: «Офтадек», «Нормакс», «Ципромед», «Софрадекс». Терапия противомикробными препаратами часто сопровождается побочными эффектами. Поэтому окулисты не назначают их детям. Средства, которые применяют для лечения детей, не должны быть токсичными. Чаще всего врачи рекомендуют «Фуциталмик» и «Сульфацетамид».
Причины астигматизма
Основная причина всех видов астигматизма – наследственная предрасположенность.
В некоторых случаях к развитию болезни могут привести:
- Травмы глаз
- Воспалительные процессы
- Неудачное хирургическое вмешательство
- Нарушение внутриглазного давления или глазного кровообращения
- Частое перенапряжение глаз
- Неблагоприятное влияние окружающей среды.
Обычно простой астигматизм является врожденным, а сложный – приобретенным.
Симптомы
Миопический астигматизм характеризуется следующими симптомами:
- Снижением остроты зрения.
- Искажением, расплывчатостью и раздвоением изображений.
- Невозможностью сконцентрировать зрение на объекте.
- Ухудшением зрения на дальнем расстоянии.
- Быстрой утомляемостью и слезливостью глаз.
- Головной болью и головокружением.
Люди, у которых диагностирован миопический астигматизм, должны подносить предметы к глазам очень близко, чтобы рассмотреть их.
Миопия и миопический астигматизм: сходство и отличие
Нередко путают миопический астигматизм и миопию, так как симптомы заболеваний сходны, особенно когда патология присутствует на обоих глазах.
При миопическом астигматизме, как и при близорукости, изображение проявляется перед сетчаткой.
Но есть между ними и различия. При миопическом астигматизме изменяется форма роговицы, а при миопии – наблюдается изменение размера и формы глазного яблока.
Диагностика болезни
Если окулист заподозрит наличие патологии, то после комплексного офтальмологического обследования он направит пациента на циклоплегию, а затем произведет повторный осмотр.
Циклоплегией называют паралич аккомодации глаза, для которого используют медицинские препараты, в основном атропин.
При комплексном обследовании оценивают остроту зрения, проверяют глазное дно, определяют рефракцию глаза и исследуют сетчатку. Пройти полное обследование вы можете в нашем медицинском центре.
Лечение миопического астигматизма
При слабой степени заболевания пациенту назначают ношение корректирующих очков или контактных линз и подбирают комплекс специальных упражнений. По желанию возможно проведение операции.
Высокую степень миопического астигматизма лучше лечить хирургическими методами.
Виды хирургического лечения
При миопическом астигматизме в качестве лечения проводят 3 вида операций:
- Астигматическая кератотомия – на роговице глаза делают микронадрезы, после заживления которых кривизна роговицы изменяется, что приводит к корректировке зрения.
- Фоторефракционная кератэктомия – с помощью лазера удаляется верхний слой роговицы и изменяется ее кривизна (два глаза можно оперировать только поочередно, восстановление зрения занимает не менее полугода).
- Лазерный кератомилез (lasik) – лазером испаряют участок в центре роговицы, что приводит к изменению ее формы (может производиться одновременно на двух глазах, зрение восстанавливается через 1-2 часа).
Если вышеперечисленные операции противопоказаны или будут неэффективными, то осуществляют пересадку роговицы, замену хрусталика либо имплантируют факичную интраокулярную линзу.
Миопический астигматизм у детей
Особое внимание следует уделить детям, так как они в основном не жалуются на ухудшение зрения. Но родителей должно насторожить, если малыш щурится, рассматривает изображения и предметы, наклоняя голову, у него часто болит голова и быстро устают глаза
Такие признаки обычно свидетельствуют о наличии астигматизма или других заболеваний глаз.
Если ребенку своевременно не произвести корректировку нарушений, то возможно развитие амблиопии – снижения зрения или косоглазия. Поэтому важна ранняя диагностика, которая возможна при регулярном посещении окулиста.
Как происходит лечение детского астигматизма читайте здесь.
Миопический астигматизм при беременности
Астигматизм обычно не оказывает никакого влияния на состояние беременной женщины. Но если он сочетается с высокой степенью миопии, то последствия могут быть серьезными.
Повышение артериального давления либо напряжение, создаваемое в процессе родов, может привести к отслойке клетчатки, что нередко становится причиной сильного ослабления зрения и даже слепоты.
Поэтому женщинам, страдающим миопическим астигматизмом высокой степени, часто противопоказана беременность либо рекомендуется кесарево сечение.
Насморк, ринит и конъюнктивит у ребенка: эффективное лечение
В первую очередь, необходимо установить, какова причина возникновения конъюнктивита, заложенности носа и насморка. Для этого стоит обратиться к врачу, который поможет определить возбудителя и назначит эффективное лечение.
Как правило, терапия сводится к устранению конъюнктивита, температуры и насморка по отдельности. Хотя все меры находятся в прямой зависимости от заболевания, которое их спровоцировало.
Вылечить насморк при рините поможет повышение влажности воздуха. Аллергический насморк требует устранения аллергенов и приема антигистаминных средств; также может проводиться чистка крови. Простудный ринит лечится антисептическими и антибиотическими спреями, сосудосуживающими каплями, иммуномодуляторами. Полезными будут ингаляции.
Лечение конъюнктивита должно иметь комплексный характер. В зависимости от причин, спровоцировавших заболевание, оно включает антибактериальные, противовирусные, противогрибковые, антипаразитарные препараты, иммуномодуляторы и антигистаминные средства.
Наиболее сложной является терапия конъюнктивита у маленьких детей, так как они часто прикасаются к глазам. Поэтому их нужно как можно чаще промывать физраствором или настоем ромашки аптечной. Воспаление конъюнктивы во время ОРВИ лечится антибактериальными средствами местного действия, компрессами и сосудосуживающими каплями.
Во время простуды конъюнктивит особенно опасен своими осложнениями. Он может привести даже к потере зрения, поэтому затягивать с лечением не стоит.
Слезные органы
Вырабатывают слезы слезные железы. Слезная железа – это парный орган, который располагается в специальном углублении в лобной кости под верхним веком каждого из глаз. Выделяемая слезинка попадает под нижнее веко, и при моргании распределяется по всему глазу. Слезы выделяются даже тогда, когда мы спим. За сутки в норме вырабатывается до 1 мл слезной жидкости. При обильном слезотечении (когда слезы, что называется, «текут ручьем») может быть выделено до 10 мл слезной жидкости (2 чайные ложки).
Слезы стекают в слезный ручей и по нему – в слезное озеро (у внутреннего угла глаза), откуда попадают в слезные канальцы, через них – в слезный мешок и выводятся по слезно-носовому протоку в носовую раковину, где, в конечном итоге, увлажняют слизистую и испаряются. Эта система называется слезоотводящими путями.
Насколько опасен конъюнктивит?
Не стоит бить тревогу, ведь, по мнению большинства офтальмологов, детский конъюнктивит не столь опасен для здоровья малыша при условии правильного и своевременного лечения. Это распространенное заболевание среди детей младшего возраста. Однако запускать болезнь не стоит, так как она может усугубиться и вызвать неблагоприятные последствия, вплоть до снижения четкости зрения. Категорически запрещено самолечение в домашних условиях.
Чтобы быстро вылечить конъюнктивит и не допустить прогрессирование заболевания до хронической формы, нужно незамедлительно посетить педиатра, а затем и офтальмолога. В том случае, если закисает один глазик и есть подозрения на дакриоцистит, желательно дополнительно проконсультироваться с отоларингологом.
Разновидности заболевания
Слизисто-гнойный конъюнктивит различают в зависимости от типа бактерий, которые вызвали воспалительный процесс. От этого напрямую зависит и симптоматика болезни. Выделяют следующие формы гнойного конъюнктивита:
- синегнойный;
- гонококковый;
- стафилококковый.
Синегнойная форма связана с попаданием на конъюнктиву синегнойной палочки. Обычно это происходит при нарушении правил гигиены или микротравм роговицы. Воспалительный процесс начинается на одном глазу и со временем может перейти на другой. Болезнь характеризуется быстрым началом и стремительным развитием. Уже в первый день заражения человек начинает испытывать боль, которая возникает при ярком свете. Вторым очевидным симптом является слезотечение.
Следующим этапом заболевания становится выделение гноя из глаз. На роговице могут образовывать поверхностные эрозии. Через них инфекция проникает внутрь роговой оболочки. Часто синегнойная форма гнойного конъюнктивита приводит к серьезным осложнениям. Наиболее типичным среди них является кератит — воспаление роговицы глаза. При несоблюдении назначенного лечения на роговой оболочке могут остаться рубцы, из-за которых снижается зрение.
Гонококковая форма заболевания у взрослых развивается вследствие попадания бактерий в организм во время полового контакта. У новорожденных симптомы болезни появляются спустя 2-3 дня после рождения, если их мать была инфицирована. Выделения гноя из глаз младенца часто содержат кровяной экссудат и сопровождаются сильным отеком век. У малышей гнойный конъюнктивит называют гонобленнореей. Она встречается довольно редко, так как беременных женщин тщательно обследуют, и при обнаружении недуга есть все шансы вылечить конъюнктивит до наступления родов.
Лечение гонококкового конъюнктивита у взрослых и детей очень важно. При отсутствии терапии эта форма заболевания может привести к полной слепоте
Даже при лечении, назначенном окулистом, болезнь часто оставляет рубцы на конъюнктиве. Опасность этой формы заболевания в том, что гонококки очень активны. Они быстро провоцируют воспалительный процесс, при запущении которого они проникают внутрь глазного яблока и могут деформировать его изнутри.
Заражение стафилококковой формой гнойного конъюнктивита обычно происходит при прямом контакте с инфицированным человеком или при использовании его личных вещей. Часто воспалительный процесс начинается после лечения заболеваний верхних дыхательных путей. Обычно он возникает спустя несколько дней после ангины или скарлатины.

Стафилококковая форма гнойного конъюнктивита развивается очень быстро. Острая фаза болезни обычно составляет от 7 до 14 дней. Если не принимать лекарства в этот период, то вылечить конъюнктивит будет весьма сложно. Заболевание может легко перейти в хроническую форму, для которой характерны ослабления симптомов и более скудные выделения гноя из глаз. Опасность хронической стадии в том, что вылечить ее гораздо труднее, чем острую.
Какие бывают отеки века?
Опухать может как нижнее, так и верхнее веко у ребенка. В чем разница? Существенной нет, но все же офтальмологи выделяют некоторые причины, по которым происходит отек либо над глазом, либо под ним. Если опухло верхнее веко, то возможно в подкожном слое скопилась жировая ткань. Также отек верхнего века сигнализирует о заболеваниях пищеварительной системы, хронической болезни почек или сердца. Причины могут крыться и в аллергических реакциях, проходящих в организме.
Вышеперечисленные причины провоцируют и отек нижнего века глаза. Однако есть мнение, что отек века (нижнего) считается одним из признаков проблем с сердечно-сосудистой системой или щитовидной железой.








Свежие комментарии